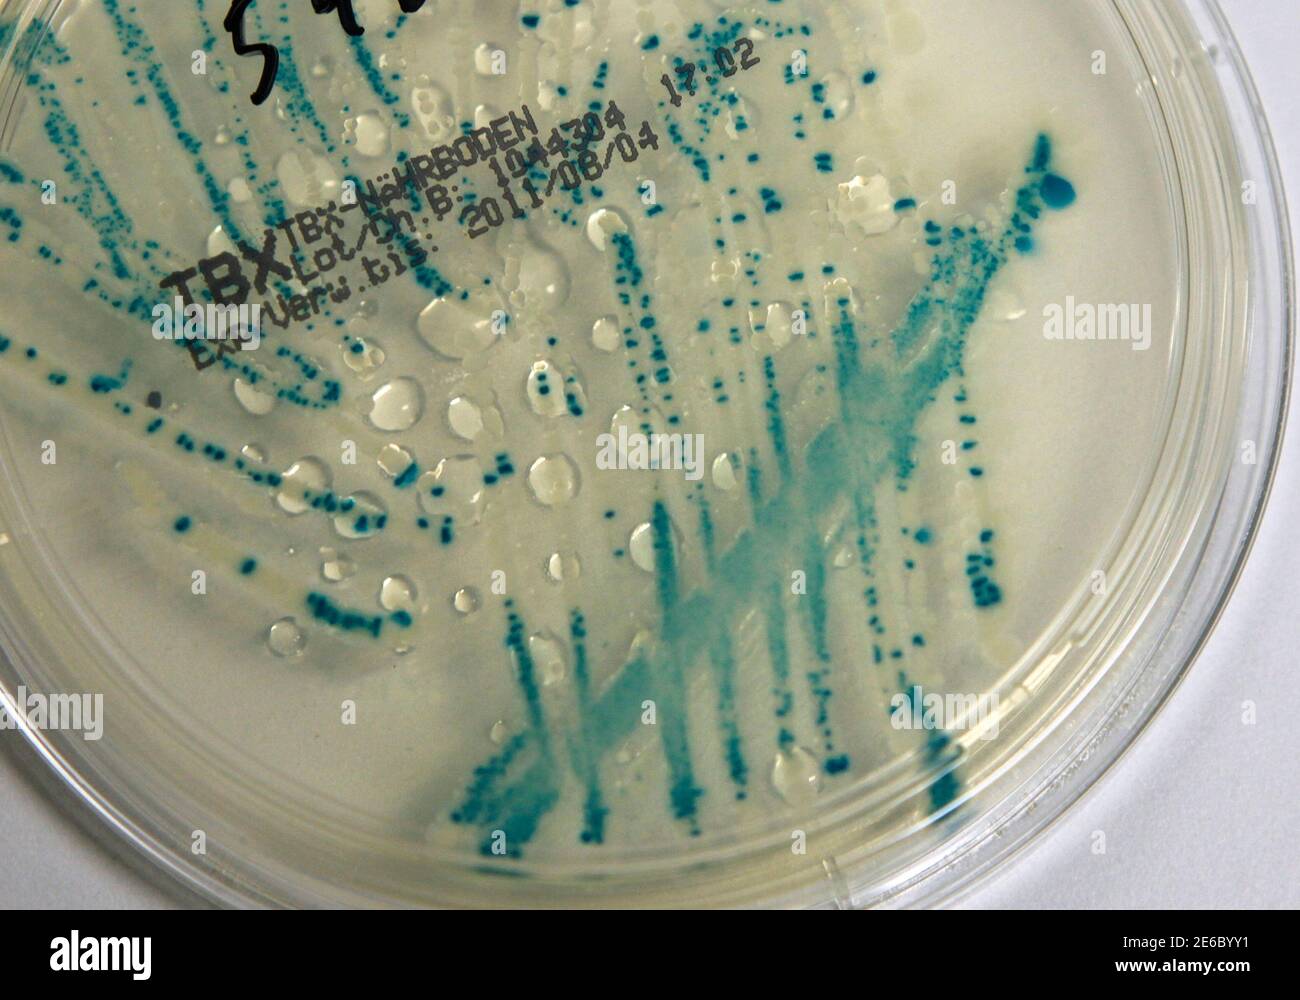

E coli препарат
Машина c8
Как перевестись в негосударственный пенсионный фонд
One track heart
Сурский самогон каталог
Сидеть пожалеть
Рассказ о фортепиано 2 класс
Resource handler
В чем лучше ехать в дороге
Шейтельман ютуб новости
Как нарисовать лабораторию
Когда будет начнется пост
Греющий кабель для водопровода установить своими руками
Бланк налогового вычета за лечение
E coli препарат 110 фотографий